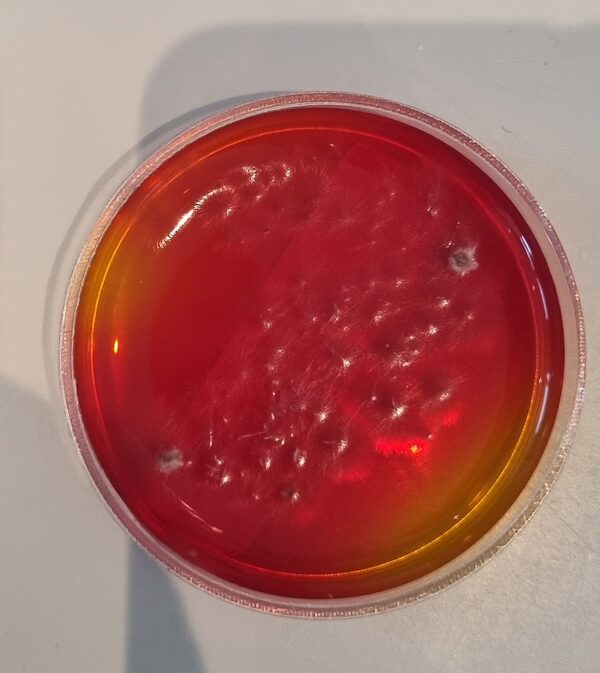
20250508_140730.jpg

Patienten

Der besondere Patient – „Taco und Leo“
Uns wurden zwei 2 1/2 Monate alte Zwergkaninchen vorgestellt. Die beiden sind kerngesund und damit das so bleibt, haben wir sie geimpft. Zum einen gegen Myxomatose und zum anderen gegen Chinaseuche (RHD 1 und 2).
Myxomatose äußert sich in Augenentzündungen, Schnupfen und Schwellungen im anogenitalbereich sowie Lungenentzündungen.
RHD zeigt sich mit inneren Blutungen und Organversagen.
Beide Erkrankungen sind weit verbreitet und führen zu schweren, meist sogar tödlichen Verläufen. Die Erreger können durch direkten Kontakt mit anderen Kaninchen, aber auch durch kontaminiertes Futter, Insekten (wie Mücken) und auch über die Kleidung und Schuhe übertragen werden.
Eine Impfung schützt ihr Kaninchen vor fatalen Verläufen.
Wir wünschen Taco und Leo ein schönes, gesundes und langes Leben!


Der besondere Patient – „Bailey“


Der besondere Patient – „Bonnie“


(1)(1).jpg)
Zum Glück besserte sich ihr Zustand schnell und sie konnte am Abend nach Hause entlassen werden.
Bei der kardiologischen Kontrolle wurden ihre Herzmedikamente angepasst und nun geht es ihr wieder gut.
Um zukünftig ein beginnendes Lungenödem frühzeitig zu bemerken, wird nun täglich Bonnies Atemfrequenz von der Besitzerin gezählt. Sollte diese über 30 pro Minute ansteigen, so ist eine umgehende Behandlung notwendig.
Wir wünschen der ganzen Familie alles Liebe!



Der besondere Patient – „Rex“
Bei Rex, einem 12 jährigen Mischlingsrüden, fiel starker Mundgeruch auf. Dies ist immer ein Warnsignal, da Tiere Beschwerden mit den Zähnen nicht kommunizieren können. Das Ausmaß des Mundgeruchs korreliert dabei meist mit dem Schweregrad der Zahnerkrankung. Keinesfalls sollte man annemen, dass Mundgeruch bei älteren Tieren normal und unproblematisch ist.
Sein Gebiss wies sehr viel Zahnstein auf und auch eine ausgeprägte Zahnfleischentzündung.
Das wahre Ausmaß zeigte sich allerdings erst nach ausführlicher Untersuchung in Narkose. Das Dentalröntgen und die Sondierung zeigten, dass bereits große Teile des Kieferknochens durch die Parodontitis verursachenden Bakterien zerstört wurde (die gelbe Linie zeigt an, wo der Kieferknochen sien sollte, die rote zeigt an wieviel Knochen bereits zerstört wurde). Dieser Knochenschwund ist leider irreversibel und in diesem Endstadium hilft nur noch die Extraktion.
Parodontitis ist aber nicht nur eine lokale Erkrankung, die zu Schmerzen, Abszessen und Kieferbrüchen führen kann, sondern betrifft den gesamten Körper, da die Bakterien durch das entzündete Zahnfleisch in die Blutbahn übergehen und dadurch in den gesamten Körper streuen.




Rex erholte sich gut von dem Eingriff und kann sein Leben nun ohne Zahnschmerzen genießen.
Wir wünschen ihm und seinem Herrchen alles, alles Gute!


Der besondere Patient – „Tiger“
Tiger ist inzwischen ein 17-jähriger Europäisch-Kurzhaar-Kater. Letztes Jahr wurde er uns im Sommer wegen chronischer Magen-Darm-Beschwerden und Gewichtsverlusts vorgestellt. Trotz seines Alters scheuten seine Besitzer keine Kosten und Mühen. Im Ultraschall zeigten sich eine verdickte Darmwände, besonders die Muskelschicht war sehr dick (rote Markierung). Um der Ursache auf den Grund zu gehen, entnahmen wir Gewebeproben. Von dem Eingriff erholte sich Tiger sehr gut und die Wunden heilten ab.
Leider ergaben die Proben, dass es sich um einen Tumor handelte.
Aber Tigers Besitzer waren wieder bereit, alles für Tiger zu tun. Er bekommt seitdem eine Chemotherapie in Tablettenform und Kortison gegen die Entzündung.


Nun war Tiger zu einer Kontrolluntersuchung bei uns und es geht ihm blendend.
Im Ultraschall ist deutlich zu sehen, dass die Darmwand nicht mehr verdickt und der Tumor unter Therapie derzeit unter Kontrolle ist.


Wir freuen uns mit Tiger und danken seinen Besitzern für Ihr Vertrauen!

Der besondere Patient – „Sammy“
Sammy, ein fast 13 jähriger Mischlings-Rüde, wurde uns wegen seines stark aufgetriebenen Bauchs vorgestellt.
Eine Röntgenuntersuchung zeigte eine Masse, die den gesamten Bauchraum ausfüllte und alle anderen Organe stark verdrängte. Sie führte bereits zu einer erschwerten Atmung.


Trotz Sammys fortgeschrittenem Alter entschied sich sein Herrchen mutig zu einer Operation.
In der Operation zeigte sich, dass es sich um eine riesige, flüssigkeitsgefüllte Masse des Gekröses handelte. Wir entfernten sie erfolgreich. Vor der Operation wog Sammy 20 kg, danach nur noch 16,2 kg. Die Masse wog also 3,8 kg. Fast ein Viertel seines ursprünglichen Gewichts.
Direkt nach der Operation schien es Sammy schon deutlich besser zu gehen.
Die histopathologische Untersuchung ergab eine gutartige Veränderung.



Wir hoffen, dass Sammy und sein Herrchen noch viele schöne gemeinsame Tage erleben können!

Der besondere Patient – „Pamuk“
Pamuk, eine 9 jährige Malteser-Hündin, wurde uns wegen einer Blutarmut vorgestellt.
Bei der Ursachenforschung zeigte sich eine hochgradig vereiterte Gebärmutter. Pamuk war die letzten drei Jahre nicht mehr läufig geworden, was bereits ein Zeichen für eine hormonelle Dysbalance sein kann, da Hündinnen keine Menopause zeigen.
Wir entfernten die Gebärmutter zusammen mit beiden Eierstöcken. Sie wogen 800 Gramm.



Pamuk war direkt nach der Operation wieder fit. Sie hat sich erstaunlich schnell erholt.
Nach 10 Tagen konnten die Fäden gezogen werden.
Wir wünschen Pamuk und ihrem Frauchen alles, alles Gute!


Der besondere Patient –"Coco“
Erinnern Sie sich an den Herbstgruß von Coco?
Sie wurde uns nun vorgestellt, da ein Milchzahn nicht ausgefallen war.

Milchzähne sollten ausfallen sobald der bleibende Zahn in die Maulhöhle durchgebrochen ist. Tut er dies nicht, so ist er dem bleibenden Zahn im Weg, was zu einer schmerzhaften Fehlstellung führen. Außerdem entdsteht eine enge Schmutznische, die Parodontitis begünstigt.
Abzuwarten ist also keine Option.
Auch das Ammenmärchen, dass Milchzähne keine Wurzel haben, ist in diesem Zusammenhang irreführend. Jeder Milchzah nhat eine Wurzel. Diese löst sich während des Zahnwechsels auf. Die Milchzähne, die man findet, besitzen also keine Wurzel mehr. Da dieser Ablauf aber gestört ist, zeigen bleibende Milchzähne häufig eine stabile und beeindruckend lange Wurzel.
Dies kann man auch auf Cocos Dentalröntgen nachvollziehen.
Wir zogen also den Milchzahn und rienigten das Gebiss.


Wir wünschen Coco, Hazel, Peanut und ihrem Frauchen noch eine schöne Winterzeit!

Der besondere Patient – „Balu“
Balu, ein 5 jähriger Boxer-Rüde, wurde uns wegen einer Schwellung am Vorderbein vorgestellt. Eine Punktion ergab einen bösartigen Mastzelltumor. Dabei handelt es sich um entartete Zellen, die eigentlich allergische Reaktionen auslösen. Leider waren die Ausmaße des Tumors bereits so groß, dass eine chirurgische vollständige Entfernung nur mittels Amputation möglich gewesen wäre.
Zum Glück hatte der Tumor noch nicht gestreut und wir entschieden uns zu einer Spritzentherapie, die ein Pflanzengift enthält und den Tumor absterben lässt. Wir wollten alles tun, um Balus Bein zu retten!
Da die Injektion unangenehm ist, legten wir Balu dafür in einen Dämmerschlaf.

Einige Tage danach löste sich das Tumorgewebe ab. Die Ausmaße wurden sichtbar und der Anblick war furchtbar.
Balu erhielt lange Schmerzmittel und er und sein Frauchen waren sehr tapfer und gaben nicht auf.
Nach gut zwei Monaten war die Wunde endlich verheilt und Balu kann wieder fröhlich und energiegeladen durchs Leben hüpfen.





.jpg)
Wir danken Balus Frauchen für das große Vertrauen in uns und die ausdauernde Geduld...es hat sich gelohnt!

"Hazel, Peanut und Coco"

„Gemma"
Bei der 9-jährigen Viszla-Mix-Hündin "Gemma" führten wir aus Vorsorgegründen eine Ultraschalluntersuchung des Bauchraums durch.
Zum einen stellten wir einen Herd in der Milz fest und zum anderen eine Nierenzyste links.
Milzherde können gutartige Knoten sein, die aber wie ein Tumor auch aufplatzen und zum Verbluten führen können. Nierenzysten sind bei Hunden glücklicherweise selten. Obwohl sie grundsätzlich gutartig sind können sie durch stetes wachstum das gesunde Nierengewebe verdrängen, zu abflussstörungen des Urins und Schmerzen führen.
Zusammen mit Gemmas Frauchen entschieden wir uns, die Milz und die Nierenzyste operativ zu entfernen.




Gemma erholte sich gut von der Operation und der Befund ergab eine Nierenrindenzyste.
Nach sechs Wochen kontrollierten wir, ob die Nierenzyste erfolgreich behandelt wurde und der Ultraschall bestätigte dies.
Wir wünschen der lieben und bei uns immer so aufgeregten Gemma und seinem Frauchen alles Liebe für die Zukunft!

„Karl"
Der 9-jährige franz. Bulldoggen-Rüde "Karl" wurde uns vorgestellt, da sein linkes Auge verändert aussah. Es zeigte sich eine Einblutung in die vordere Augenkammer. Weitere Untersuchungen zeigten leider, dass das Auge bereits durch eine Netzhautablösung erblindet war. Die Ursache war ein Tumor, weshalb das Auge nicht mehr zu retten war und entfernt werden musste.
-min.jpg)

Der Tumor erwies sich leider als bösartig.
Aber die Wunde verheilte gut und wir hoffen sehr, dass der Tumor noch nicht gestreut hatte.

Wir wünschen dem tapferen Karl und seinem Frauchen alles Liebe!

„Blacky"
Bei dem 12-jährigen Jack-Russel-Terrier "Blacky" fiel bei einer Impfung auf, dass sein Bauch sehr groß und hart war. Die Besitzer hielten ihn für dick.
Eine Ultraschalluntersuchung zeigte eine große Masse im Bauchraum, die bereits andere Organe verdrängte.
Die Besitzer entschieden sich für eine Probelaparotomie. Hierbei wird der Bauchraum in Narkose eröffnet.
Es zeigte sich, dass Blacky eine riesige, gutartige Fettgeschwulst im Bauch hatte. Wir konnten sie erfolgreich entfernen.

Die gutartige Fettmasse wog 850 g. Nach der Operation war Blacky wieder rank und schlank.

Dem süssen Blacky und seinen lieben Besitzern wünschen wir alles, alles Liebe für die Zukunft!


„Kasper"
Bei dem 3-jährigen Europäisch-Kurzhaar-Kater "Kasper" fiel bei einer Impfung auf, dass ein Eckzahn abgebrochen war.
Auch wenn nur eine kleine Ecke fehlte, rieten wir dazu, dies mittels einer Untersuchung in Narkose und einem Dentalröntgen weiter abzuklären.
Jeder abgebrochene Zahn ist schmerzhaft und kann zu einer Infektion des Zahns führen und sollte deshalb immer versorgt werden.
Im Zahnröntgen zeigte sich leider, dass obwohl nur die Spitze des Zahns abgebrochen war (roter Feil), das Lebendige des Zahns (die Pulpa) betroffen war und der Zahn längst abgestorben war. Dies zeigt sich im Seitenvergleich durch eine erweiterte Pulpenkammer (blaue Markierung).



In diesem Stadium konnte der Zahne leider nur noch gezogen werden.
Kasper geht es wieder gut und er hat nun keine Zahnschmerzen mehr.

Wir wünschen Kasper alles Liebe und dass er sein Leben wieder ohne Schmerzen genießen kann!

„Tiger"
Bei Tiger, einem 9 jährigen Europäisch-Kurzhaar-Kater, fielen lange Oberkiefereckzähne auf- Vampirzähne?
Leider nicht. Beim genaueren Betrachten fiel auf, dass das Zahnfach stark aufgetrieben und entzündet war. Die beiden Zähne waren schwer erkrankt und dadurch aus dem Zahnfach geschoben worden. Im Vergleich ist ein gesunder Eckzahn im Röntgen dargestellt.
Katzen können Zahnschmerzen nicht zeigen und leiden stumm. Daher sind regelmäßige Untersuchungen sehr wichtig.





In diesem Stadium konnten die Zähne leider nur noch gezogen werden.
Tiger geht es wieder gut und er hat nun keine Zahnschmerzen mehr.
Wir wünschen Tiger und seiner Familie alles Gute!

Erinnern Sie sich an unseren „Chui"?
Chui ist ein inzwischen 16jähriger Rüde. Wir hatten ihn wegen eines riesigen Tumors im Bauchraum erfolgreich operiert und seitdem ging es ihm sehr gut.
Nun wurde er uns wegen einer einseitigen Schwellung der rechten Wange vorgestellt. Es handelte sich um einen Wurzelspitzenabszess eines großen Backenzahns.


Sein Frauchen wollte keinesfalls, dass Chui unter Zahnschmerzen leiden musste - auch wenn er diese nicht zeigen konnte. Hunde und Katzen leiden bei Zahnschmerzen für uns Menschen stumm. Der Schmerz ist aber genau so schlimm wie für uns Menschen und auch wenn betroffene Patienten noch fressen und spielen, so mindert es doch ganz wesentlich deren Lebensqualität.
Also zogen wir unter Vollnarkose den betroffenen Zahn. Somit ist Chui geheilt und muss keine Zahnschmerzen mehr haben.
Alles, alles Gute für unseren lieben Chui und sein mutiges Frauchen!

Der besondere Patient – „Mailo“
Mailo, ein fast 5 jähriger unkastrierter Labradorrüde wurde uns vorgestellt, da er unklare Magen-Darm-Symptome hatte. Außerdem zeigte er Gewichtsverlust. Eine symptomatische Therapie brachte leider keine Besserung, weshalb wir Diagnostik einleiten mussten. Die Bildgebung (Röntgen und Ultraschall des Bauchraums) verlief unauffällig. Erst eine spezielle Blutuntersuchung ergab die Diagnose: exokrine Pankreasinsuffizienz (EPI). Dies bedeutet, dass Mailos Bauchspeicheldrüse leider nicht mehr ausreichend Verdauungsenzyme produziert. Meist ist dies auf eine chronische Entzündung zurückzuführen, die lange unentdeckt bleiben kann. Diese EPI führt zu fettigem Durchfall in großen Mengen mit Gewichtsverlust trotz starkem Appetits.

Nun bekommt Mailo sein Futter mit einem Pulver vermischt, welches Verdauungsenzyme enthält und es geht ihm wieder gut.

Wir wünschen dem immer fröhlichen und braven Mailo und seinem Frauchen alles Liebe!

Der besondere Patient – „Magnum“
Magnum, ein fast 14 jähriger kastrierter Waldkatzenmix wurde uns vorgestellt, da er unter Inappetenz, Durchfall und Gewichtsverlust litt. MIttels Bildgebung (Ultraschall des Bauchraums) diagnostizierten wir einen Dünndarmtumor.

Operativ entfernten wir den Darmtumor. Glücklicherweise verheilte die Wunde gut und die Untersuchung ergab, dass es sich zwar um einen bösartigen Tumor handelte, wir ihn aber im Gesunden entfernt hatten.




Magnum hat nun wieder Appetit und ist kaum wiederzuerkennen. Wir wünschen ihm und seinem Frauchen alles, alles Liebe!

Der besondere Patient – „Katze“
Uns wurde eine Fundkatze vorgestellt, die unter Juckreiz an der Nase litt.
Die klinische Untersuchung zeigte Krusten auf dem Nasenrücken.
Schnell ergab sich der Verdacht auf einen Hautpilz.
Dies bestätigte sich sowohl in der Pilzkutlur als auch mittels einer speziellen Untersuchungslampe, wobei die Pilzhyphen apfelgrün leuchten.

Nun findet eine mehrwöchige Behandlung mit lokalen und oralen Pilzmedikamenten inklusive Umgebungsbehandlung statt.
Dies ist nicht nur für den Patienten wichtig, sondern auch für uns Menschen, da es sich um eine Zoonose handelt...
Gute Besserung für das Fundkätzchen!


Der besondere Patient – „Kimba“
Uns wurde Kimba, ein 13jähriger EKH-Kater, aufgrund einer schlecht einstellbaren Schilddrüsenüberfunktion vorgestellt. Er erhielt bereits ein Medikament, um das Schilddrüsenhormon zu senken. Trotz einer bereits hohen Dosis ließ sich der Wert aber nicht mehr senken.
Bei der klinischen Untersuchung fiel links am Hals eine stark vergrößerte Schilddrüse auf.
Etwa 10 % der älteren Katzen leiden an einer Schilddrüsenüberfunktion, die meist durch einen gutartigen Tumor bedingt ist. Zu den Symptomen zählen: Gewichtsverlust trotz gesteigertem Appetit, Erbrechen, Durchfall, Hyperaktivitiät und vermehrtes Trinken und Urinieren. Folgen der Schilddrüsenüberfunktion sind unter anderem ein Nierenleiden sowie eine Herzerkankung und Bluthochdruck. Bei 70 % der Katzen sind beide Schilddrüsen davon betroffen.
Der Goldstandard der Therapie ist eine Radiojodtherapie. Dabei wird auch versprengtes Schilddrüsengewebe behandelt und eine Heilung ohne weitere Medikamente ist so möglich.
Nur ca. 2 % der Schilddrüsentumore bei Katzen sind bösartig. Dies ist wahrscheinlicher je älter die Katze, je größer der Tumor und je länger die Erkrankung besteht.
Wir entschieden uns, das veränderte Schilddrüsengewebe zu entfernen.




Glücklicherweise fiel der Befund des Pathologen gut aus. Es handelte sich um einen gutartigen Tumor.
Auch das Schilddrüsenhormon war wieder gut einzustellen und Kimba war deutlich agiler.

Wir wünschen Kimba und seinem Herrchen alles Gute und betreuen ihn gerne weiterhin in der Praxis...


Der besondere Patient – „Milo“
Milo, ein 5 jähriger Kater, wurde uns vorgestellt, da er plötzlich blutigen Urin absetzte.
Zum Glück taten die Besitzer es nicht einfach ab und stellten ihn vor. Da der Urin stark blutig war, führten wir weiterführende Untersuchungen durch, um die Ursache zu klären. Im Ultraschall zeigten sich große Blutansammlungen und eine Urinuntersuchung ergab keinen Hinweis auf eine Infektion.
Um eine Gerinnungsstörung z.B. durch eine Rattengiftaufnahme auszuschließen, leiteten wir eine zusätzliche Blutuntersuchung ein.




Und tatsächlich hatte Milo sich versehentlich mit einem Cumarinderivat vergiftet.
Die Aufnahme von sogenannten Cumarinderivaten führt drei bis vier Tage später zu einer massiven Blutungsneigung, auch plötzliche Todesfälle sind möglich. Ohne eine Therapie mit Vitamin K verläuft eine solche Vergiftung meist tödlich.
Wir behandelten ihn entsprechend. Da das aufgenommene Präparat unklar blieb, wird er nun mehrere Wochen sicherheitshalber Zuhause Vitamin K erhalten.
Wir freuen uns, dass es Milo wieder gut geht und hoffen, dass er noch mindestens 6 Katzenleben übrig hat!


Der besondere Patient – „Malo“
Bei einer klinischen Untersuchung fielen uns bei dem 6jährigen Rüden Malo gleich mehrere sehr kleine Hautwucherungen auf. Optisch sahen sie alle gleich aus. Da man durch reines Tasten aber nie sicher sagen kann, ob es sich um eine einfache Warze oder doch um einen Hauttumor handelt, entnahmen wir Proben.



Leider stellte sich heraus, dass es sich nur bei einem der Hautknoten um eine gutartige Veränderung handelte. Die anderen beiden waren sogenannte Mastzelltumore. Mastzellen kommen auch bei gesunden Tieren in der Haut vor und vermitteln allergische Reaktionen. Entarten diese Zellen aber, handelt es sich um bösartige Tumore, die auch innere Organe befallen und zum Tod des Hundes führen können.
Glücklicherweise hatten wir sie früh entdeckt und sie hatten noch nicht gestreut. Wir entfernten sie erfolgreich im Gesunden.

Nun drücken wir Malo und seinem Frauchen inklusive Nachwuchs alles, alles Liebe und drücken die Daumen, dass Malo keine weiteren Tumore entwickelt.

Der besondere Patient – „Niya“
Niya, eine 3jährige EKH-Katze wurde uns als Notfall vorgestellt, da ihr Schwanz versehentlich in einer Tür eingeklemmt wurde. Auf den ersten Blick sah dieser nicht besonders schlimm aus. Nach einer Rasur zeigte sich aber das ganze Ausmaß des Traumas.


Der hintere Teil des Schwanzes musste leider amputiert werden. Niya überstand die Operation gut und die Wunde verheilte.


Nun kann sie ihr Leben auch mit einem Luchsschwanz wieder genießen!

Der besondere Patient – „Taya“
Taya, eine fast 3 jährige, weiblich-kastrierte Hündin, wurde uns wegen chronischen Erbrechens vorgestellt. Die Gabe von Magensäureblockern und auch eine Magen-Darm-schonende Diät hatten nur vorübergehend zu einer Besserung geführt.
Blutuntersuchungen und auch Bildgebung verliefen unauffällig.
Daher entschieden wir uns dazu, eine sogenannte Probelaparotomie durchzuführen. Dazu legten wir Taya in Narkose und eröffneten den Bauchraum.
Sofort fielen zwei feste Gegenstände im Magen auf. Nach der Eröffnung des Magens zeigten sich ein Ball sowie ein kleiner Holzstock.
Beide waren im Röntgen nicht sichtbar.
Nach der Entfernung der beiden Fremdkörper vernähten wir den Magen und die Bauchdecke wieder.


Direkt nach der Operation ging es Taya sehr gut und sie zeigte keinerlei Symptome mehr.
Wir wünschen Taya und ihrem Frauchen alles, alles Liebe und hoffen, dass Taya nicht wieder auf die Idee kommt, Fremdkörper zu schlucken!


Der besondere Patient – „Alba“
Alba, eine 1jährige weibliche Kaninchendame, wurde uns zur Kastration vorgestellt. Es ging ihr gut, sie zeigte keinerlei Symptome.
Gründe, die für die Kastration von weiblichen Kaninchen sprechen sind:
Zysten, chronische Gebärmutterveränderungen (glandulär-zystische Endometriumhyperplasie - GZEH), Gebärmutterentzündung, Gebärmutterkrebs sowie Brustkrebs.
Gebärmutterkrebs (Adenokarzinome) ist der häufigste Krebs der unkastrierten Kaninchen und das Risiko steigt deutlich mit zunehmendem Alter. So sind bis zu 80 % der über vier Jahre alten weiblichen Kaninchen davon betroffen, weshalb wir zu einer vorsorglichen Kastration mit sechs Monaten raten.
Bei Böckchen hingegen spricht aus medizinischer Sicht nichts pauschal für eine Kastration.
Trotz des noch recht geringen Alters von Alba zeigten sich veränderte Eierstöcke (schwarze Markierung) sowie eine Zyste an der Gebärmutter (türkise Markierung).

Wir entfernten beide Eierstöcke und die Gebärmutter. Eine histopathologische Untersuchung wurde von den Besitzern nicht gewünscht.
Die Wundheilung verlief gut.

Alba erholte sich sehr gut von dem Eingriff und wir hoffen, dass der Eingriff früh genug erfolgte und sie somit geheilt ist.
Alles Liebe für Alba und ihre Familie!
.png)

Der besondere Patient – „Chui“
Chui, ein 13jähriger großer Mischlingsrüde, kam zu uns, da er Beschwerden beim Laufen hatte.
Bei der Untersuchung fiel auf, dass sein Bauch sehr hart und aufgetrieben war.
Die Röntgenuntersuchung zeigte eine riesige Masse in seinem Bauch.

Mittels Ultraschall konnte die Organzugehörigkeit nicht sicher festgestellt werden.
Trotz Chuis hohem Alter entschied sich sein Frauchen für eine gewagte Operation.
Es zeigte sich, dass es sich um einen 5 kg schweren Tumor der Milz handelte. Dieser konnte erfolgreich im Ganzen entfernt werden.
Der histopathologische Befund ergab ein Hämatom, also eine Einblutung. Dieser Befund ist nur mit Vorsicht Anlass zur Erleichterung, da es sich bei diesem Fall mit Sicherheit um einen Tumor handelte. Dies ist für den Pathologen aber nicht immer sicher feststellbar.




Chui und auch sein Frauchen haben sich aber zum Glück gut von der großen OP erholt.
Wir wünschen ihnen noch viele wunderschöne gemeinsame Tage!


Der besondere Patient – „Beta“
Beta, eine 5 Monate alte, weibliche Malinois-Hündin, wurde uns wegen einer Gebissproblematik vorgestellt. Beide Unterkiefereckzähne bißen in den Oberkiefer ein. Diesen Zustand bezeichnet man als Caninussteilstand oder auch Mandibula angusta. Dies ist schmerzhaft und verhindert ein Längenwachstum des Unterkiefers. Außerdem bißen auch mehrere Schneidezähne ein.
Zusammen mit der Besitzerin besprachen wir die möglichen Optionen. Die betroffenen Zähne zu ziehen, würde das Problem endgültig lösen. Aber die Wurzeln der Eckzähne beim Hund sind beeindruckend lang und verleihen dem Kiefer Stabilität. Außerdem sind sie wichtig zum Festhalten, halten die Zunge zurück und verleihen Selbstbewusstsein.
Wir entschlossen uns also zu einer kieferorthopädischen Maßnahme.
Hierfür war es notwendig, die betroffenen Schneidezähne zu ziehen. Dann verlängerten wir die Unterkiefereckzähne in die gewünschte Position. Durch den Druck beim Schließen des Fangs werden die Zähne langsam und schmerzlos in die gewünschte Richtung bewegt - wie bei einer Zahnspange.




Obwohl die Kronenverlängerungen nicht die geplante Zeit hielten, waren die Maßnahmen ausreichend, um einen normalen und schmerzlosen Kieferschluss zu erreichen.



Wir wünschen Beta und ihrem Frauchen alles Gute!


Der besondere Patient – „Jack“
Jack, ein 5 Monate alter, männlicher franz. Bulldoggen-Rüde, wurde uns wegen einer starken Schwellung und Rötung beider Augen vorgestellt. Die Tränendrüsen der Nickhäute waren vorgefallen. Dies zeigt sich in einer kugeligen, geröteten Schwellung innen am Auge. Aufgrund der Ähnlichkeit zu einer Kirsche spricht man auch von einem "Cherry-eye".
Der Vorfall führt zu einer chronischen Entzündung, was schmerzhaft ist und die Sicht einschränkt.
Früher entfernte man die Drüse einfach. Dies wird nicht mehr empfohlen, da diese Drüse etwa 40 % der Tränenflüssigkeit bildet und es daher nach einer Entfernung zu einem trockenen Auge kommen kann.
Daher versenkten wir die Drüse in einer zuvor chirurgisch geformten Tasche (Pocket-Technik nach Morgan) und vernähten diese.

Die Fäden mussten nicht gezogen werden, da es sich um selbstauflösendes Nahtmaterial handelte.
Leider zeigte Jack bereits kurz nach der Operation erneut einen teilweisen Vorfall der Nickhautdrüsen.
Dies ist durch den viel zu kurzen Schädel und die kaum vorhandene Augenhöhle dieser Rasse in Kombination mit einer vergrößerten Drüse bedingt.
Zumindest bereitet ihm dies aber keine Unannehmlichkeiten mehr.


Wir raten vom Kauf von extrem gezüchteten Tieren ab, um ihnen viel Leid zu ersparen...
Wir sind aber gerne weiter für Jack und seine Familie da und wünschen alles Gute!

Der besondere Patient – „Lilo“
Lilo, eine 10 Monate alte, weibliche Europäischkurzhaarkatze, wurde uns mit Geburtsstörungen vorgestellt. Sie hatte zuvor in Abwesenheit der Besitzer zwei Kitten zur Welt gebracht. Eines wurde leider schwer verletzt und musste eingeschläfert werden. In einer Tierklinik wurde dann außerdem festgestellt, dass es ein drittes Kitten gab. Aufgrund der Größe wurde zu einem Kaiserschnitt geraten.

Die Besitzer kamen daraufhin mit Lilo zu uns und wir machten einen Versuch mit Hilfe eines wehenstimulierenden Hormons (Oxytozin), um einen Kaiserschnitt zu umgehen. Da sich eine Stunde nach der Verabreichung noch immer nichts tat, entschieden wir uns nun doch den Kaiserschnitt durchzuführen. Als wir Lilo hochnahmen, um sie auf den OP-Tisch zu setzen, flutschte uns das Kitten in die Hände - so ein Glück!


Wir wünschen Lilo und ihren Kitten alles, alles Liebe!

Der besondere Patient – „Anton“
Anton, ein 4 jähriger Dobermann Rüde, wurde uns zur Kontrolle eines wurzelkanalbehandelten Zahnes vorgestellt. Da hierfür eine Narkose erforderlich war, führten wir vorher eine Herzabklärung durch.
Eine Röntgenuntersuchung verlief unauffällig. Bei der Ultraschalluntersuchung des Herzens (Echokardiographie) zeigten sich leider Veränderungen einer dilatativen Kardiomyopathie - DCM.
Hierbei handelt es sich um eine Erkrankung des Herzmuskels, welche mit einer verminderten Pumpleistung und einer Vergrößerung des Herzens einhergeht. Beim Dobermann ist diese Erkrankung genetisch bedingt. Andere betroffene Rassen sind beispielsweise Doggen, Neufundländer, Bernhardiner und irische Wolfshunde. Auch durch eine Mangelernährung mit Taurin oder Carnitin kann die Erkrankung entstehen.
Etwa jeder zweite Dobermann ist von der Erkrankung betroffen und jeder Dritte davon stirbt an einem plötzlichen Herztod, wenn die Erkrankung zu spät erkannt wird.




Anton und sein Freund Karl fanden die Untersuchung zum Glück offensichtlich sehr entspannend.
Er bekommt nun ein Herzmedikament, welches die Schlagkraft des Herzens verbessert und deutlich seineÜberlebenszeit trotz seiner Herzerkrankung verlängert und er wird in sechs Monaten zur Herzkontrolle vorgestellt.
Wir hoffen, dass es Anton und auch seinem Freund Karl noch lange sehr gut gehen wird!



Der besondere Patient – „Mila“
Mila, eine 7jährige, weiblich-kastrierte Europäischkurzhaarkatze, wurde uns mit dem Verdacht auf eine Harnblasenentzündung vorgestellt. Bei einer Ultraschalluntersuchung fiel auf, dass ein Harnstein die Ursache für ihre Beschwerden war. Dies machte eine umgehende Operation notwendig, damit Mila nicht weiter unter Schmerzen leiden musste.

In Vollnarkose wurden Bauchraum und Harnblase eröffnet. Der Harnstein wurde entfernt


Nach einer längeren Erholungsphase kann Mila nun wieder ihr Leben ohne Schmerzen genießen...wir wünschen ihr und ihren Besitzern alles Gute!

Der besondere Patient – „Charly“
Charly, ein elfjähriger Labradorrüde, wurde uns wegen einer Umfangsvermehrung am Augenlid vorgestellt. Bei der klinischen Untersuchung fiel darüber hinaus auf, dass er an Parodontose und Zahnfleischwucherungen litt. Dies alles sollte unter Vollnarkose behandelt werden.
Wie bei allen älteren Patienten rieten wir vor der Narkose zu mehreren Untersuchungen:
- eine Blutuntersuchung verlief unauffällig
- auch eine Röntgenuntersuchung des Brustkorbs verlief unauffällig
- eine Ultraschalluntersuchung des Bauchraumes aber zeigte eine stark veränderte Milz...
Wir rieten also dazu statt der geplanten Operation vorsorglich sofort die Milz zu entfernen. Der Besitzer war glücklicherweise sofort einverstanden. Somit entfernten wir umgehend die Milz. Diese war auch schon mit bloßem Auge sichtbar verändert.


Leider ergab die Untersuchung des Pathologen, dass es sich um einen bösartigen Tumor, ein sogenanntes Hämangiosarkom, handelte. Dieser Tumor geht von den Blutgefäßen aus und hat zumeist schon gestreut, wenn die Diagnose gestellt wird. Aufgrund von Charlys Alter und der geringen Aussicht auf eine vollständige Heilung entscheid sich sein Besitzer gegen eine Chemotherapie. Zumindest aber kann Charly nun nicht mehr durch ein plötzliches Aufplatzen des Tumors verbluten. Dabei hätten sich die Tumorzellen im gesamten Bauchraum verteilt.
Derzeit geht es Charly gut und wir hoffen, dass dies noch lange so ist.


Aus gegebenen Anlaß möchten wir Ihnen "Loki" vorstellen.
Loki wurde uns als Notfall in der Samstagsprechstunde vorgestellt, da sein aufmerksamer Besitzer glücklicherweise beim Spaziergang bemerkt hatte, dass Loki eine unbekannte, weiße Substanz gefressen hatte. Sie befand sich auf einem Karton, auf dem mit Klebstoff eine tote Maus fixiert war.


Dies war circa 30 Minuten vorher geschehen. Da die Chancen somit gut standen, dass die Substanz durch Erbrechen noch aus dem Körper herauszuholen sein wird, entschied sich der Besitzer gegen eine Magenspülung.
Nachdem wir Loki untersucht hatten, verabreichten wir ihm umgehend ein Medikament, welches Erbrechen auslöste. Daraufhin erbrach Loki eine ganze Handvoll von der weißen Substanz. Nachdem er danach nur noch gallig erbrach, bekam er ein Medikament, welches den Armen von seiner Übelkeit befreite. Zur Sicherheit erhielt er noch Aktivkohle für Zuhause, um gegebenenfalls Reste der Substanz zu binden und auszuscheiden.
Nachdem bereits vor Wochen mehrfach Giftköder in Dreieich gefunden wurden, möchten wir hiermit erneut auf die Gefahr aufmerksam machen.
Sollten Sie einen Giftköder finden, dokumentieren Sie dies und erstatten Anzeige bei der Polizei. Den Giftköder bitte einsammeln und bei der Polizei vorzeigen, um zu verhindern, dass ein anderes Tier (auch Wildtiere und Kinder sind in Gefahr) zu Schaden kommt...
Wir wünschen allen Vier- und natürlich auch Zweibeinern schöne Feiertage!

Der besondere Patient – „Puma“
Puma, ein etwa einjähriger Britischkurzhaarkatzer, wurde uns als Fundkatze mit einer schweren Verletzung vorgestellt. Seine Rute war so schwer traumatisiert, dass die Schwanzwirbel zu sehen waren. Somit war klar, dass eine Amputation notwendig sein würde.
Glücklicherweise kommen Katzen auch ohne vollständigen Schwanz gut zurecht - auch wenn er eine gute Balancierhilfe ist.


Wir legten Puma also in Vollnarkose und setzten den Schwanz ab, erhielten dabei so viel wie möglich.
Leider tolerierte Puma nach dem Eingriff weder Haslrkagen noch einen Verband und schaffte es so, sich die Schwanzwunde zwei Mal wieder aufzubeißen und musste jedes Mal erneut operiert werden.
Es wurde klar: eine weitere Operation sollte nicht notwendig werden. Also verliefen Pumas erste Tage der Wundheilung nach der dritten Operation unter strenger tierärztlicher Aufsicht.


So verheilte Pumas Wunde endich vollständig und er konnte neue Besitzer finden.
Wir wünschen ihm von ganzem Herzen ein toles Leben!

Der besondere Patient – „Betty“
Betty wurde uns wegen einer derben Schwellung unterhalb des linken Auges vorgestellt. Dies ist meist die Folge eines entzündeten Backenzahns, wodurch ein Abszess von der Wurzelspitze durch den Knochen nach außen durchbricht. In diesem Fall sahen die Zähne aber bis auf eine geringfügige Zahnfleischentzündung und etwas Zahnstein unauffällig aus. Um dies weiter abzuklären, war eine Narkose notwendig. Nur so konnten die Zähne vollständig untersucht und auch geröntgt werden.


In Vollnarkose fiel auf, dass der vierte Backenzahn innen gebrochen war (roter Pfeil). Im Dentalröntgen waren große Wurzelspitzenabszesse zu sehen (blaue Pfeile). Durch die Kronenfraktur waren Bakterien ins Innere des Zahns gelangt und hatten diesen inifziert. Dies ist sehr schmerzhaft. Leider haben Hunde keine Möglichkeiten Zahnschmerzen zu äußern, sie leiden also stumm. Auffällig wurde es erst als der Abszess nach außen sichtbar wurde, was bereits eine lange Leidensdauer voraussetzt. In diesem Fall war es nicht sinnvoll, den Zahn durch eine Wurzelkanalbehandlung zu erhalten. Daher zogen wir den Zahn (die drei Zahnwurzeln wurden separat entfernt, damit keine Reste im Kiefer verblieben) und verschlossen die Wunde mittels Naht. Betty erhielt noch einige Tage Antibiose und Schmerzmittel.

.png)

Jetzt kann Betty wieder schmerzlos kräftig zubeißen. Alles Gute für sie!


Der besondere Patient – „Kenny“
Bei Kenny, einem Chihuahua-Rüde, stellten wir fest, dass nicht alle Milchzähne ausgefallen waren und bleibende Zähne fehlten.
Bleibende Milchzähne sind problematisch, da diese zum einen ein erhöhtes Risiko aufweisen abzubrechen (was genau so schmerzhaft ist wie bei einem bleibenden Zahn) und zum anderen den bleibenden Zähnen im Weg sind und somit zu Gebissfehlstellungen führen können (im Gegensatz zum Menschen dienen die Milchzähne nicht als Platzhalter). Außerdem kommt es durch die nicht ausgefallenen Milchzähne häufig zu einem Zahnengstand, der wiederum die Entstehung von Parodontose begünstigt.
Fehlende bleibende Zähne haben vier mögliche Ursachen. Entweder sie waren nie angelegt oder sind vollständig ausgefallen. In diesen beiden Fällen besteht kein Handlungsbedarf. Die anderen beiden Ursachen sind, dass der Zahn entweder abgebrochen (und somit schmerzhaft und ein Infektionsherd) oder im Kiefer stecken geblieben ist. Dies muss mittels Dentalröntgenbildern abgeklärt werden.
Wir entschieden uns also zu einer Zahnbehandlung in Vollnarkose. Dabei wurden die verbliebenen Milchzähne (blau markiert) gezogen. Auf den Dentalröntgenbildern fiel auf, dass ein bleibender Zahn im Kiefer feststeckte (rot markiert). Dieser würde nach einigen Jahren zur Entstehung einer Knochenzyste beitragen, welche wiederum zu Kieferbrüchen und auch Krebs führen kann. Den verbliebenen Zahn zu ziehen wäre aber sehr herausfordernd gewesen, da er sich auf Höhe eines Kanals im Knochen befand, in dem ein großes Gefäß verläuft und somit ein starkes Blutungsrisiko bestände.


Wir entfernten stattdessen den Milchzahn, um dem im Kieferknochen steckenden Zahn einen Weg nach draußen zu ermöglichen.
Bei einer Kontrolle nach einigen Monaten stellten wir sehr erfreut fest, dass der Zahn tatsächlich durch den Kiefer in die Mundhöhle durchgebrochen war (rote Markierung).



Nun kann Kenny sorglos sein Leben weiterhin genießen und wir wünschen ihm alles Liebe!


Die besondere Patientin – „Malou“
Malou, eine 15 Monate alte Cane Corso Hündin wurde uns vorgestellt, da sie seit zwei Wochen ihre erste Läufigkeit zeigte. Dabei verlor sie viel Blut und der Besitzerin fiel ein unangenehmer Geruch auf.
Bei der klinischen Untersuchung zeigte sich die Vulva entsprechend ihres Zyklusstandes leicht geschwollen und ein dunkles, blutiges, aber übelriechendes Sekret trat aus der Scheide. Bereits da war klar, Malou braucht Hilfe. Wir leiteten Diagnostik ein.
Die Blutwerte zeigten eine 10fache Erhöhung des Entzündungseiweiß sowie eine Blutarmut und eine Erhöhung der weißen Blutkörperchen.
Bei einer Ultraschalluntersuchung war ein mit Eiter gefüllter Hohlraum im Bereich der Gebärmutter darstellbar.




Zunächst stabilisierten wir die Patientin mittels Tropf und Schmerzmitteln. Dann begannen wir mit der Operation. Es zeigte sich, dass die Gebärmutterhörner und Eierstöcke unauffällig waren, aber der Gebärmutterhals hochgradig erweitert und voller Eiter war.
So weit wie möglich setzten wir das veränderte Gewebe ab und entfernten dabei auch Gebärmutter und Eierstöcke.



Danach spülten wir den Bauchraum mehrmals, um möglichst keine Entzündungszellen im Bauchraum zurückzulassen.
Malou konnte nach der Operation mit Schmerzmittel und Doppelantibiose wieder nach Hause gehen.
Die Kontrolluntersuchungen zeigten eine konstante Besserung der Entzündungsanzeichen und die Wunde verheilte zum Glück gut.
Eine pathologische Untersuchung ergab eine Entzündung des Gebärmutterhalses durch Eierstockzysten. Sie war also geheilt.
Wir wünschen Malou von Herzen alles Gute!


Die besondere Patientin – „Ginger“
Ginger, eine 1,5jährige weibliche Perserkatze, wurde uns zur Kastration und Abklärung einer Lahmheit hinten rechts vorgestellt.
Bei der Untersuchung fiel eine Entzündung des Hauptballens der rechten Hinterpfote auf. Zunächst entnahmen wir eine Gewebeprobe zur weiteren Diagnostik. Der Pathologe hatte leider keine guten Nachrichten. Ginger war trotz ihres geringen Alters an einem sehr bösartigen Tumor erkrankt, der ohne eine Amputation des Beines zu ihrem Tod geführt hätte. Wir entschieden uns also zu einer Amputation, um Ginger zu retten.



Ginger überstand den Eingriff gut und die Wunde verheilte komplikationslos.

Nun hüpft sie auf drei Beinen glücklich durchs Leben...


Der besondere Patient (oder besser: die besondere Patientin) – „Ernie“
Ernie ist ein 5 Monate alter Hamster, der die letzten Tage ein Rückzugsverhalten zeigte und schlapp war.
Bei der Untersuchung fiel zunächst auf, dass es sich wohl viel mehr um eine Erna handelte. Außerdem trat beim Abtasten des Bauchs Eiter aus der Scheide.
Eine Ultraschalluntersuchung bestätigte den Verdacht einer Gebärmutterentzündung.
Gebärmuttervereiterung kommen häufiger bei Hamsterdamen vor und führen unbehandelt zum Tode. Eine Operation behebt sicher die Ursache, nämlich meist eine aufsteigende Infektion durch hormonelle Imbalancen, birgt aber auch das Narkoserisiko. Alternativ kann eine Behandlung mit Medikamenten (Antibiose, Schmerzmittel, Antiprogesteron) versucht werden. Diese birgt allerdings das Risiko eines Nierenversagens und einem erneuten Auftretens.
Da die Besitzerin bereits einen Hamster durch diese Erkrankung verloren hatte, entschied sie sich für eine Operation. Wir entfernten also die Eierstöcke und die vereiterte Gebärmutter in Vollnarkose.



Ernie überstand den Eingriff sehr gut und wurde danach schnell wieder wach.

Eine Nachbehandlung mit Schmerzmittel und Antibiose erfolgte und nun kann sie hoffentlich noch viele schöne Hamsterjahre verbringen…


Die besondere Patientin – „Hops C“
Hops C, ein 3jähriges weiblich-kastriertes Kaninchen, wurde uns vorgestellt, da sie plötzlich sehr apathisch war und sich kaum noch bewegte.
Ihre Körpertemperatur war bereits stark erniedrigt und die Maden wimmelten nur so.


Wir legten sie in Narkose, wuschen und schoren sie, entfernten jede einzelne Made und desinfizierten die betroffenen Stellen. Sie erhielt ein Medikament, welches noch verbliebene Maden abtöten würde sowie ein Breitsprektrumantibiotikum, einen Entzündungshemmer, ein starkes Schmerzmittel (Oiopid), Infusion und ein antiparasitäres Medikament.

Zum Glück hatten die Besitzer Hops C noch rechtzeitig vorgestellt. Der Befall mit Fliegenlarven verläuft nämlich früher oder später durch eine Blutvergiftung tödlich.
Sie erholte sich gut.
Wir raten allen Kaninchenbesitzern einmal täglich auch die Unterseite ihres Kaninchens zu kontrollieren und immer frühzeitig bei Urin- oder Durchfallproblemen bei einem Tierarzt vorstellig zu werden, um diese furchtbare Erkrankung zu vermeiden – vor allem im Sommer!


Der besondere Patient – „Bombay“
Der 2-jährige Britisch Kurzhaar Kater Bombay wurde uns vorgestellt, da dem Besitzer eine Blutspur auf dem Boden aufgefallen war.
Bei der klinischen Untersuchung fiel ein vorgefallener Anus („Prolaps ani“) auf. Dies erforderte ein schnelles Handeln, da der vorgefallene Darm anschwillt, austrocknet und absterben kann.
In Narkose verlagerten wir den Darm zurück und verhinderten ein erneutes Vorfallen mit Hilfe einer Tabaksbeutelnaht. Da Bombay eine vergrößerte Prostata aufwies, wurde er außerdem kastriert. Eine Kotuntersuchung verlief unauffällig. Nach fünf Tagen wurden die Fäden gezogen und seitdem geht es Bombay gut.



Der besondere Patient – „Bailey“
Als sein Frauchen sich Bailey beim Züchter aussuchte, war ihr bewusst, dass die schöne Fellfarbe durch einen Gendefekt bedingt ist. Sie hoffte, dass er trotzdem nicht erkranken würde und ein fröhlicher, schöner Hund sein würde. Dass diese Züchtung meist größere Probleme als nur eine Haarlosigkeit (Farbmutantenalopezie) verursachen kann, soll Baileys Geschichte beispielhaft zeigen.
Mit knapp 14 Wochen erkrankte er an einer lebensbedrohlichen viralen Erkrankung, der Parvovirose – trotz zweimaliger Impfung. Dies machte einen langen und kostspieligen stationären Aufenthalt notwendig, aber er konnte gerettet werden.

Im ersten Lebensjahr hatte er dann seinen ersten, aber leider nicht letzten epileptischen Anfall. Eine MRT-Untersuchung des Kopfes ergab die Diagnose: idiopathische Epilepsie. (Eine Ursache konnte nicht gefunden werden.)
Daraufhin wurde eine Kastration aufgrund der Epilepsie durchgeführt. Außerdem entwickelte er Juckreiz am ganzen Körper und hatte immer wieder Ohrenentzündungen.


Er wird mit antientzündlichen Medikamenten sowie Physiotherapie (auch Aquatrainer) behandelt. Danach wurde mit einer Ausschlussdiät aufgrund der sich verschlechternden allergischen Hautbeschwerden (Juckreiz und Ohrenentzündungen) begonnen. Bailey hat eine Futtermittelallergie.
Mit 1,5 Jahren trat eine Verschlechterung seiner Epilepsie ein, welche die Gabe von antiepileptischen Medikamenten erforderte. Diese Therapie ist kostspielig und lebenslang.
Seit dem dritten Lebensjahr leidet Bailey außerdem an einer chronischen Nierenerkrankung, woraufhin sein Futter erneut angepasst werden musste und regelmäßige Kontrollen (Blut-, Urin- und Ultraschalluntersuchungen sowie Blutdruckmessungen) erfolgen müssen.
Dann wurde eine aufwendige Umstellung seiner Epilepsiemedikamente aufgrund einer Verschlechterung seiner Anfälle notwendig.
Im Sommer erlitt Bailey einen lebensbedrohlichen anaphylaktischer Schock aufgrund eines Insektenstiches mit stationärem Aufenthalt, wovon er sich glücklicherweise erholte. Ein erneuter Stich einer Biene oder Wespe könnte tödlich ausgehen, weshalb sein Frauchen nun immer ein Notfallmedikament (Epipen) bei sich tragen muss.

Außerdem zeigten sich bei Routineblutkontrollen erhöhte Leberwerte, die die Gabe von Leberschutzpräparaten notwendig machten.
Bailey wird mit zahlreichen Medikamenten und Physiotherapie sowie regelmäßigen tierärztlichen Kontrollen unterstützt, um ihm trotz seiner vielen Baustellen ein erträgliches Leben zu ermöglichen. Dies ist sehr kosten-, zeitintensiv und mental belastend. Seine monatlichen Medikamentenkosten belaufen sich derzeit auf 370 Euro, seine Futterkosten auf 90 Euro, reine Tierarztrechnungen beliefen sich auf fast 50.000 Euro…
Wir raten davon ab, einen silbernen Labrador zu kaufen und damit die Vermehrung zu unterstützten, um solchem Leid vorzubeugen.
Bailey und seinem Frauchen wünschen wir natürlich nur das Beste und helfen immer gern.

Die besondere Patientin – „Bärbel“


Noch am selben Abend konnte Bärbel bereits weiches Futter zu sich nehmen.

Bei der Kontrolluntersuchung 3–4 Wochen nach der Operation zeigte sich die Frakturlinie durchbaut.
Nach 6 Wochen konnten die Drähte in Kurznarkose entfernt werden. Die betroffenen Zähne konnten leider nicht erhalten werden, aber der Bruch war gut verheilt. Nun kann Bärbel wieder kräftig zubeißen.


Der besondere Patient – „Amani“

Direkt vor der Harnblase war eine inhomogene Masse zu sehen (blauer Pfeil), die am ehesten der Milz zuzuordnen war. Da die Masse bereits sehr groß war, war eine eindeutige Organzugehörigkeit jedoch nicht sicher möglich.
Kurzentschlossen entschieden sich die Besitzer für eine Operation.
In der Operation zeigte sich, dass die Masse tatsächlich vom Milzschwanz ausging und bereits oberflächlich eingerissen war. Die Entfernung der Milz führten wir mit äußerster Vorsicht durch, damit es nicht zu einer Blutung kam. Dank unseres bipolaren chirurgischen Verödungsgeräts war die Operation bereits nach 30 Minuten abgeschlossen.

Amani wurde wach und wurde mit Schmerzmittel nach Hause entlassen. Nun hieß es abwarten, da der Befund des Pathologen etwa eine Woche brauchen würde.
Dann kam endlich das Ergebnis: Zum Glück handelte es sich lediglich um einen Altersknoten.
Wir hatten Amani also mit der Operation geheilt. Ohne die zeitnahe Operation wäre er bald daran verblutet.
Wir freuen uns mit den Besitzern über den guten Befund und wünschen Amani alles Gute!


Der besondere Patient – „Keanu“
Trotz einer initialen Behandlung mit einem Mittel gegen Übelkeit und Infusion verschlechterte sich sein Zustand. Er war apathisch und wollte weiterhin nichts zu sich nehmen.
Die klinische Untersuchung zeigte, dass er ausgetrocknet und sein Bauch schmerzhaft war. Im Ultraschall zeigte sich, dass er an einer Einstülpung des Darmes litt.

Dies ist eine seltene Erkrankung, häufig sind Maine Coon Katzen betroffen. Dabei stülpt sich der Dünndarm wie ein Strumpf in sich selbst hinein (blauer Pfeil) und bewirkt dadurch einen Darmverschluss. Die Ursache bleibt häufig ungeklärt. Parasiten, Darmentzündung und Tumore können Auslöser sein.

Keanu wurde notoperiert.
Ohne eine umgehende Operation verläuft der Darmverschluss tödlich. Der betroffene Darmabschnitt konnte nur noch entfernt werden, da er nicht mehr richtig durchblutet war. Die beiden Darmenden wurden sorgfältig miteinander vernäht und die Naht auf Dichtigkeit kontrolliert.



Die besondere Patientin – „Chichi“
Bei der klinischen Untersuchung fiel ein Scheidentumor auf, der sich bereits vorwölbte und leicht blutete. Er war bereits so groß, dass er auf die Mündung der Harnröhre drückte und so die Urinabsatzbeschwerden und Gangauffälligkeiten verursachte.
Eine Blutuntersuchung zeigte, dass die Nierenwerte bereits erhöht waren. Nun war klar: Chichi muss schnell geholfen werden. Sie wurde in Vollnarkose von uns operiert. Ein Dammschnitt war nötig, um den gut walnussgroßen Tumor überhaupt vollständig vorlagern zu können.

Zur besseren Übersicht und Schonung der Harnröhre wurde ein Harnkatheter gelegt. Dank unseres fortschrittlichen, bipolaren Elektrochirurgiegeräts konnten wir den Tumor schnell ohne größere Blutungen entfernen. Der Dammschnitt wurde vernäht und Chichi kam schnell wieder zu sich.

Was für eine Erleichterung wieder Urin lassen zu können!
Die Wunde verheilte komplikationsfrei und der Pathologe hatte gute Nachrichten: Es handelte sich um einen gutartigen Tumor, den wir im Gesunden entfernt haben.
Vaginaltumore bei Hündinnen sind relativ selten. Es sind vor allem ältere, unkastrierte Hündin betroffen. Meist handelt es sich um gutartige Tumore, aber auch bösartige Formen kommen vor. Symptome sind Scheidenausfluss, Belecken der Vulva, vermehrter Urinabsatz und blutiger Urin.


Die besondere Patientin – „Emma“
Da ihr Zustand sich unter symptomatischer Therapie nicht besserte, leiteten wir Diagnostik ein. Eine Blutuntersuchung ergab eine auffällige Verschiebung der Elektrolyte. Das Natrium-Kalium-Verhältnis war erniedrigt.

Im Ultraschall zeigten sich beide Nebennieren sehr klein:

Wir führten einen Stimulationstest zur Bestätigung der Verdachtsdiagnose durch.


Die Nebennieren waren trotz Gabe eines stimulierenden Hormons nicht in der Lage, ausreichend Kortisol zu bilden (<0,2 bedeutet nicht messbar niedrig).
Was ist also die Ursache der Addison Krankheit?
Die Nebennieren sind zwei kleine Drüsen in der Nähe der Nieren. Sie bilden wichtige Hormone wie Cortisol und Aldosteron. Die Ursache der Erkrankung können Autoimmunkrankheiten, Tumoren, Verletzungen, Arzneimittelnebenwirkungen, Infektionen oder Entzündungen sein. Folglich werden Cortisol und meist auch Aldosteron nicht ausreichend produziert. Diese Hormone sind lebenswichtig für den Stoffwechsel, die Aufrechterhaltung des Blutdrucks, den Flüssigkeits- und Elektrolythaushalt sowie für die Reaktion auf Stress. Wenn der Hund diese Hormone nicht ausreichend produziert, erkrankt er. Sehr niedrige Hormonspiegel sind lebensbedrohlich.
Glücklicherweise ist die Erkrankung behandelbar.
Emma muss nun lebenslang etwa monatlich eine Spritze erhalten und täglich Kortison-Tabletten sowie regelmäßige Kontrolltermine wahrnehmen. Damit kann sie ein schönes und langes Hundeleben führen…


Der besondere Patient – „Der Fritz“
Bei der klinischen Untersuchung wurde direkt eine Verschmutzung mit Kot sowie eine Schwellung am Po sichtbar. Der Anus war so klein, dass kaum ein Fieberthermometer hineinpasste. Wie sollte also eine normale „Wurst“ hindurch passen?

Schnell war klar: Fritz muss schnell geholfen werden, da er so nicht lange würde überleben können. Langfristig würde ein lebensbedrohlicher Darmverschluss entstehen.
Zunächst wurden Röntgenbilder in zwei Ebenen angefertigt, um zu beurteilen, ob noch weitere Probleme vorlagen. Glücklicherweise zeigte sich, dass lediglich eine Weichteilengstelle bestand (blauer Pfeil) mit dahinter angeschopptem Kot (blauer Kreis), Darm und Becken aber normal ausgebildet waren.

Bei einem zu eng angelegtem Anus spricht man von einer Atresia ani, auch Analstenose, wobei es sich um eine äußerst seltene angeborene Missbildung handelt.
Um dem Kleinen helfen zu können, war eine Vollnarkose notwendig. Er erhielt einen Venenzugang, wurde intubiert, erhielt eine Dauertropfinfusion und wurde an die Überwachung angeschlossen. Zusätzlich erhielt er ein starkes intravenöses Schmerzmittel, da Eingriffe am Anus sehr schmerzhaft sind.
Zunächst dehnten wir vorsichtig mit konischen Instrumenten, Gleitcreme und viel Geduld den Anus so lange bis ein Schlauch hineinpasste. In den Schlauch integriert befand sich ein aufblasbarer Ballon. Dieser wurde mittels Spritze so aufgeblasen, dass der Analring einriß, was mit einer kleinen Blutung einherging. Sofort danach war eine rektale Untersuchung mittels kleinem Finger problemlos möglich.


Direkt nach dem Aufwachen nahm Fritz schon wieder dankbar Leckerlis an und tollte durch die Praxis. Allerdings musste die Behandlung noch einmal wiederholt werden bis die Öffnung groß genug war.
Nun kann er ein ganz normales Hundeleben führen.

